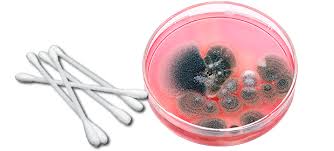

lowes air purifier canada
Ashlin Technology Solutions Inc. Royal Sovereign 20" High Vel... Dyson AM07 Tower Fan Dyson AM06 Desk Fan Emerson Indoor Ceiling CF200... Emerson Midway Eco CF-955 Honeywell Mini Tower HWLHY20... EasyAcc Mini USB Mobile Sile... Hunter Bayport 42 Inch White... Color / Finish:Black 18-in 3-Speed Oscillation Stand Fan Specs: Adjustable tilt Adjustable height CFM (CFM): 1854 Fan Type: Stand Indoor / Outdoor:... Finish:Black/Iron 10-in 10-Speed Oscillation Desk Fan No Blades, no choppy air Safe, no fast spinning blades Touch tilt, pivots on its own centre... Color / Finish:White 20-in 3-Speed Box Fan Specs: Lightweight Compact design CFM (CFM): 1877 Construction Material: Plastic Fan Type: Box Fan... Finish:Bronze, Glass Color:Frosted, Light Bulb:(2)40w B10 Cand F Incand 36-in Bronze Flush Mount Ceiling Fan Features 36-in bronze motor housing... Finish:Black 12-in 3-Speed Oscillation Desk Fan 120V 60Hz 55W 3 speed settings Wide-angle oscillation Adjustable vertical tilt Safety grill Easy...

Color / Finish:Walnut, Light Bulb:(3)60w G16 Cand F Incand DRP HB 44-IN CEDAR HILL HUGR WLNT 44-inCedar Hill Ceiling Fan, Walnut 5 reversible... Finish:Satin Nickel, Fan Blade:Satin Nickel, Light Bulb:LED Perceptor 48-in Hugger Style Integrated LED Light Kit Ceiling Fan Hidden mounting... Finish:Copper Bronze, Glass:Etched White, Blade Finish:Dark Bronze, Light Bulb:(1)75w T4 Mini Can 120v Halogen Adrian 44 Flushmount DC Ceiling Fan... Finish:White 12-in Oscillating Desk Fan Easy detachable and combinative Piano push button switch Both oscillating and tilting angle function PP... Finish:White 36-in 3-Speed Oscillation Tower Fan Space saving design Specs: 3 speeds CFM (CFM): 591 Fan Type: Tower Indoor / Outdoor: Indoor Number... Finish:Yellow and Black Stanley Utility Blower Fan Includes: Pivoting blower head Rugged easy to carry handle Comes fully assembled Specs: CFM... Finish:Brushed Nickel, Light Bulb:(2)40w B10 Cand F Incand Hunter fans are engineered for optimum air movement, painstakingly designed and...

Finish:Black 5 Speed Quiet Set Tower75 Deg Oscillation for wider angle coolingCFM (CFM): 110Construction Material: PlasticFan Size (Inches): 40Fan... Finish:Gold Rowenta VU2531U2 Turbo Silence 12-in Table Fan Turbo Silence 12-in Oscillating Table Fan 5 Aerodynamic blade with a streamlined design... Finish:New Bronze, Shade:Crme Organza, Blade Finish:Walnut, Light Bulb:(4)40w B10 Cand F Incand Veranda 21 Ceiling Fan Remote Downrod: 6H x 3/4Dia.... Blade Style:Wide Oval - 18-in, Blade Finish:Natural Palm Leaf, Finish:Antique Brass These blades include Natural Palm leaf sets (not for damp... Blade Finish:Walnut/Light Walnut, Finish:Satin Nickel Simple yet effective, the Edgewood by Fanimation is a great fan for those looking for an... Finish:Satin Black, Blade Finish:Satin Black 52 Canfield Patio Fan Features: 172mm x 20mm AC induction motor Hot dip galvanized undercoat Stainless... 52-in Oak and White Ceiling Fan Blade Blade Finish:Walnut 70-inCeiling fan blade set For use exclusively with the 70-inMonarch ceiling fan Screw packs included Reversible solid wood

Finish:Black/Aluminum 16-in Digital Oscillating Portable Stand Fan This Ecohouzng 16 Digital Oscillating Stand Fan is ideal for medium to large...
ionic air purifier dangers Fan Blade:Elmwood, Finish:Architectural Bronze, Glass:Opal White, Light Bulb:(1)75w T4 G9 120v Halogen The Treo Ceiling Fan 52' blade span Dual...
air purifier sharp jakarta Finish:Brushed Nickel, Blade Finish:Maple /Marive Cherry Canfield 44' CeilingFan 172mm x 20mm AC induction motor 16 degree blade pitch 44' blade...
aaa air duct and carpet cleaning reviews Finish:Polished Nickel In four steps you can completely customize the Arkwright Dcor ceiling fan to your personal style: simply choose the fan body... Finish:Bronze Accent The Islander is a classic Fanimation fan that has been redesigned with modern sophistication.

The updated Islander features... Finish:Oil-Rubbed Bronze, Blade Finish:Oil-Rubbed Bronze, Glass :Opal Frosted, Light Bulb:(1)100w T4 Mini Can 120v Halogen Embrace the Embrace by... Finish:Tannery Bronze, Diffuser:Citrine, Blade Finish:Cherry/Walnut, Light Bulb:(3)60w B10 Cand C Incand The Larissa ceiling fan captures the... Finish:White Powder Coat, Blade Finish:White Canfield 30 Ceiling Fan Features: 153mm x 17mm AC induction motor 24degree blade pitch 30 blade sweep... Fan Blade:Royal Walnut, Finish:Satin Nickel, Glass:Opal White, Light Bulb:(1)75w T4 G9 120v Halogen The Treo Ceiling Fan 52' blade span Dual... Finish:Burnished Bronze, Blade Finish:Rosewood/Dark Walnut, Light Bulb:(4)15w B9 Cand F Incand Yellowstone 56' Ceiling Fan with 14 Degree Blade... Finish:Weathered Steel Powder Coat, Blade Finish:Walnut/Teak 52 Canfield Patio Fan Features: 172mm x 20mm AC induction motor Hot dip galvanized... Finish:Antique Pewter, Blade Finish:Light Cherry/Dark Cherry, Diffuser:Fresnel Lens, Light Bulb:(4)40w T3 Cand 120v Krypton 52 Kittery Point...

Finish:Oil Brushed Bronze, Blade Finish:Walnut/Cherry, Diffuser:Citrine, Light Bulb:(3)40w B10 Cand F Incand Windham 52 Indoor/Outdoor Flush Mount... Finish:Weathered Patina, Blade Finish:Washed Oak/Pine Log Cabin 52' Ceiling Fan with 13 Degree Blade Pitch 5 Plywood Reversible Blades 172x16mm... Finish:Oil Brushed Bronze, Blade Finish:Walnut/Cherry Canfield 44' CeilingFan 172mm x 20mm AC induction motor 16 degree blade pitch 44' blade sweep... Finish:Oiled Burnished Bronze, Glass:Brushed Cognac, Blade Finish:Charred Oak/Walnut, Light Bulb:(3)60w B10 Cand F Incand 52' Cabernet Ceiling Fan... Blade Type:Bamboo Leaf (Damp), Blade Finish:Antique, Blade Style:Wide Oval - 18-in The Caruso fan blade set. 10 blades All Weather and Bamboo... 52 -in blade arms Polished brass finish For ceiling fan Easy to install 5-pack Finish:Black, Size:Short Neck The Brewmaster carries on Fanimation's reputation for reproducing unusual, yet functional, belt-drive fans. Fan Blade:Oil Brushed Bronze/Black Cherry, Finish:Oil Brushed Bronze, Glass:Caspian, Light Bulb:(3)40w B10+(4)15w B8 Cand F Incand The Calavera...